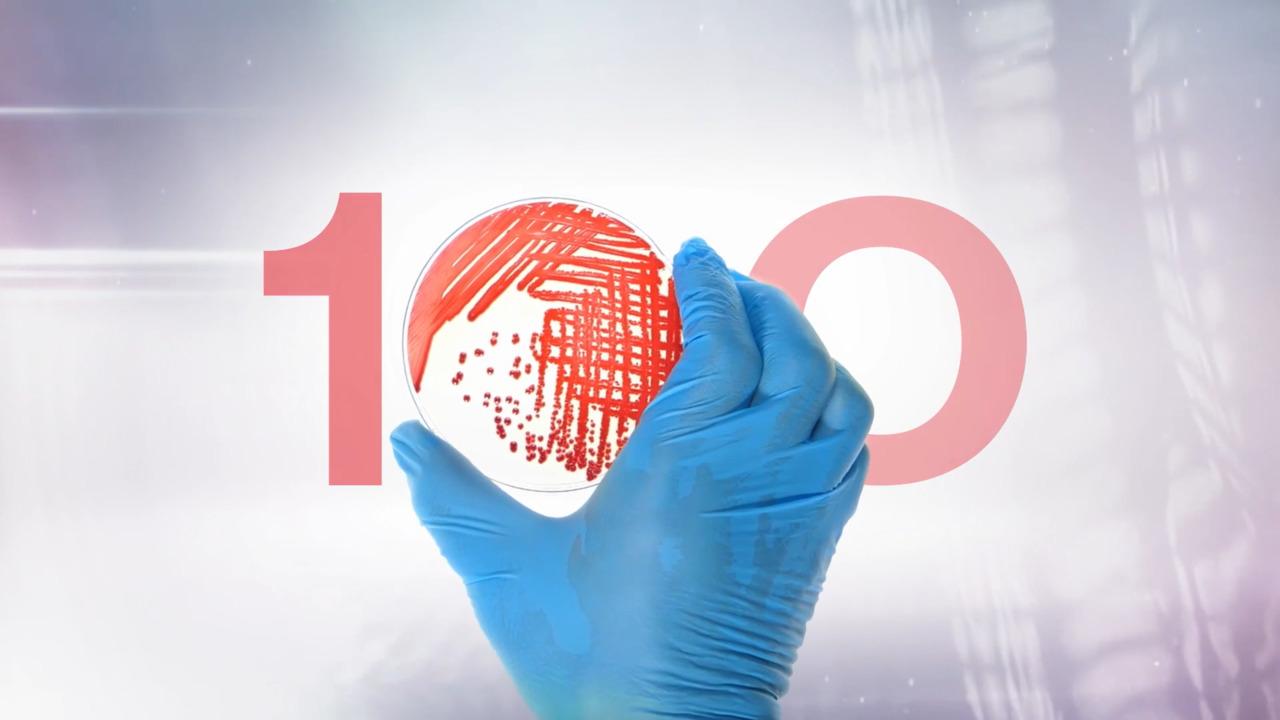

Search
At the core of culture media
For 100 years, we have been dedicated to serving microbiologists in their pursuit of discovery. From antibiotic resistance monitoring, to safeguarding the integrity of the global food supply chain, our tools have aided microbiology leaders in their essential work since 1924 .
Today, Thermo Scientific™, Oxoid™, Remel™ and other microbiology products are part of the Thermo Fisher Scientific Speciality Diagnostics portfolio. Our products, known for their rigorous quality standards, support the Thermo Fisher Mission: To enable our customers to make the world healthier, cleaner and safer.
The story so far: Aiding microbiology leaders since 1924
- Early 1900s
- 1940s
- 1960s
- Late 20th century
- Today
The future of microbiology manufacturing
Since 1924, we have been dedicated to producing high-quality culture media, from essential raw materials to pre-prepared culture media products. Recent investments in our facilities ensure that we continue to deliver a variety of products with industry-leading standards of quality, consistency, and control.
Today, we have various manufacturing sites operating as global hubs for microbiological production. From a core set of base peptone formulations to culture media, in addition to a variety of diagnostics kits, assays and reagents, we supply a wide range of premium products for applications in clinical diagnostics, food safety and authenticity and pharmaceutical manufacturing. These products serve a global network of customers, helping to advance science across diverse sectors.
To further strengthen Thermo Fisher Scientific’s position as a leader in the life sciences industry and industrial applications, we have invested into new state-of-the-art manufacturing facilities to meet the growing global demand for high-quality microbiology products.
At Thermo Fisher Scientific Microbiology we are committed to driving innovation and excellence, now and into the future.
Latest news
The updated plant was officially opened on November 14th 2023 during a ribbon-cutting event, led by Colin Drummond, Senior Director Operations and Basingstoke Site leader; Andy Stickland, Vice President Operations; Claire Wallace, President RSD Division; and Gianluca Pettiti, Executive Vice President.
With attendance from press, government and employees, the opening ceremony marked the beginning of the latest chapter in our extensive history of culture media and peptone production.
- 1
- 2
- 3
- 4
- 5
- 6